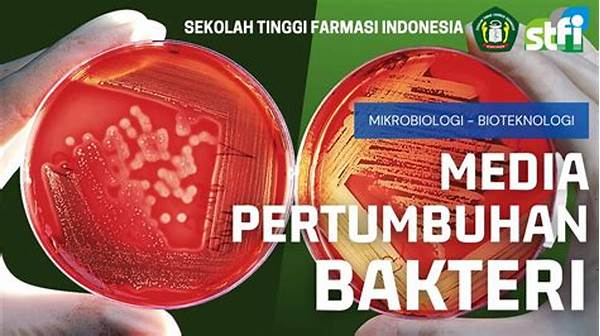
pengaruh-media-kental-pada-bakteri_42e1f3378.jpg

Media pertumbuhan bakteri sangat penting untuk mendukung penelitian dan aplikasi bioteknologi. Media kental, salah satu jenis media, memiliki peran unik dalam memengaruhi pertumbuhan dan karakteristik bakteri. Artikel ini akan mengupas lebih dalam tentang bagaimana media kental mempengaruhi bakteri dalam berbagai kondisi.
Komposisi Media Kental
Media kental merupakan formulasi yang lebih padat dibanding media cair. Pada media ini, penambahan agen pengental seperti agar-agar menciptakan lingkungan yang lebih stabil bagi bakteri untuk tumbuh. Komposisi ini berpengaruh langsung terhadap pengaruh media kental pada bakteri, dimana energi yang diperlukan untuk bergerak menurun. Bakteri di media ini tampak lebih cenderung untuk membentuk koloni dibandingkan pertumbuhan individual. Media kental juga memungkinkan bakteri lebih mudah diamati dalam pembentukan biofilm, struktur yang seringkali membuat bakteri lebih resisten terhadap antibiotik.
Secara alamiah, dalam media kental, bakteri memiliki kesempatan lebih besar untuk berinteraksi satu sama lain, yang dapat meningkatkan pertukaran genetik. Hal ini menjadi salah satu alasan pengaruh media kental pada bakteri dalam meningkatkan variasi genetis yang sering dijumpai dalam eksperimen laboratorium. Selain itu, tingkat ketersediaan oksigen dan nutrisi juga dapat diatur lebih detail dalam media ini, yang mana berperan penting dalam studi interaksi bakteri dengan lingkungannya.
Keunggulan Media Kental untuk Penelitian
1. Stabilitas Struktur: Media kental mencegah penyebaran bakteri terlalu cepat, memungkinkan observasi yang lebih mudah.
2. Koloni Teramati Jelas: Memperlihatkan formasi koloni bakteri yang lebih jelas.
3. Biofilm Formation: Menguji kemampuan bakteri membentuk biofilm.
4. Pertukaran Genetik: Mendukung peningkatan interaksi genetik antar bakteri.
5. Kontrol Nutrisi dan Oksigen: Memungkinkan kontrol yang lebih presisi terhadap lingkungan.
Tantangan dalam Menggunakan Media Kental
Pengaruh media kental pada bakteri memang memberikan berbagai keuntungan, namun juga menghadirkan tantangan tersendiri. Salah satu tantangan utama adalah difusi nutrien yang lebih lambat dibandingkan dengan media cair. Ini dapat membatasi pertumbuhan bakteri tertentu yang membutuhkan akses cepat ke nutrisi. Oleh karena itu, formulasi media kental harus tepat agar dapat memenuhi kebutuhan bakteri yang diteliti.
Selain itu, pengaruh media kental pada bakteri juga berkaitan dengan kemampuan beberapa bakteri untuk mengatasi kekentalan tersebut. Bakteri dengan flagella, misalnya, mungkin menemukan kesulitan untuk bergerak. Ini bisa menghambat penelitian yang bergantung pada kemampuan pergerakan bakteri. Namun, untuk studi yang fokus pada interaksi lokal bakteri atau pembentukan koloni, media ini sangat tepat.
Variasi Pengaruh Media Kental pada Berbagai Jenis Bakteri
Setiap bakteri mungkin berespons berbeda terhadap kekentalan media. Beberapa bakteri mungkin memanfaatkan kekentalan untuk beradaptasi lebih baik terhadap lingkungan. Sementara itu, bakteri lain mungkin mengalami stress atau respon shock karena perubahan viskositas.
Secara umum, pengaruh media kental pada bakteri sangat tergantung pada jenis bakteri serta kondisi lingkungan lain yang melingkupinya. Beberapa penelitian menunjukkan bahwa bakteri gram-negatif mungkin lebih terpengaruh oleh perubahan medium ini dibandingkan gram-positif.
Observasi dan Inovasi dalam Penggunaan Media Kental
Mempelajari pengaruh media kental pada bakteri memberikan wawasan penting. Sebagai contoh, peneliti dapat menguji daya tahan bakteri terhadap antibiotik dengan lebih baik dalam media ini. Ada juga potensi innovasi di bidang pertanian dan lingkungan melalui rekayasa bakteri yang mampu merubah zat berbahaya menjadi bahan yang tidak berbahaya.
Eksperimen terbaru menunjukkan bahwa penggunaan media kental juga dapat dimanfaatkan untuk menguji metabolisme bakteri tertentu yang berfungsi dalam pembersihan limbah industri. Dengan adaptasi medium yang tepat, diharapkan lebih banyak aplikasi dapat dikembangkan dari pengaruh media kental pada bakteri ini.
Aspek Praktis Penggunaan Media Kental
Pengaruh media kental pada bakteri tidak hanya berguna dalam penelitian tetapi juga pada industri seperti makanan dan obat-obatan. Dalam produksi yogurt, contohnya, pemahaman tentang media ini membantu optimasi pertumbuhan bakteri lactobacillus. Demikian pula, produsen antibiotik menggunakan media kental untuk menstabilkan pertumbuhan bakteri penghasil antibiotik.
Secara praktis, metode ini juga sering digabungkan dengan teknik fermentasi, dimana kekentalan medium memainkan peran dalam kontrol reaksi dan stabilitas produk akhir. Memahami pengaruh media kental pada bakteri membantu industri ini berinovasi dan menjalankan proses produksi dengan lebih efisien.
Kesimpulan
Secara keseluruhan, pengaruh media kental pada bakteri menunjukkan pentingnya memahami interaksi bakteri dengan lingkungan fisiko-kimia sekitarnya. Meskipun memberikan tantangan, kelebihan media kental meliputi kontrol lingkungan yang lebih ketat, pengamatan yang lebih jelas dari fenomena biologis, hingga aplikasi komersial yang bervariasi. Dengan mempelajari lebih dalam penggunaan media kental ini, kita dapat meningkatkan efisiensi riset laboratorium serta optimasi industri yang bergantung pada aktivitas mikroorganisme.